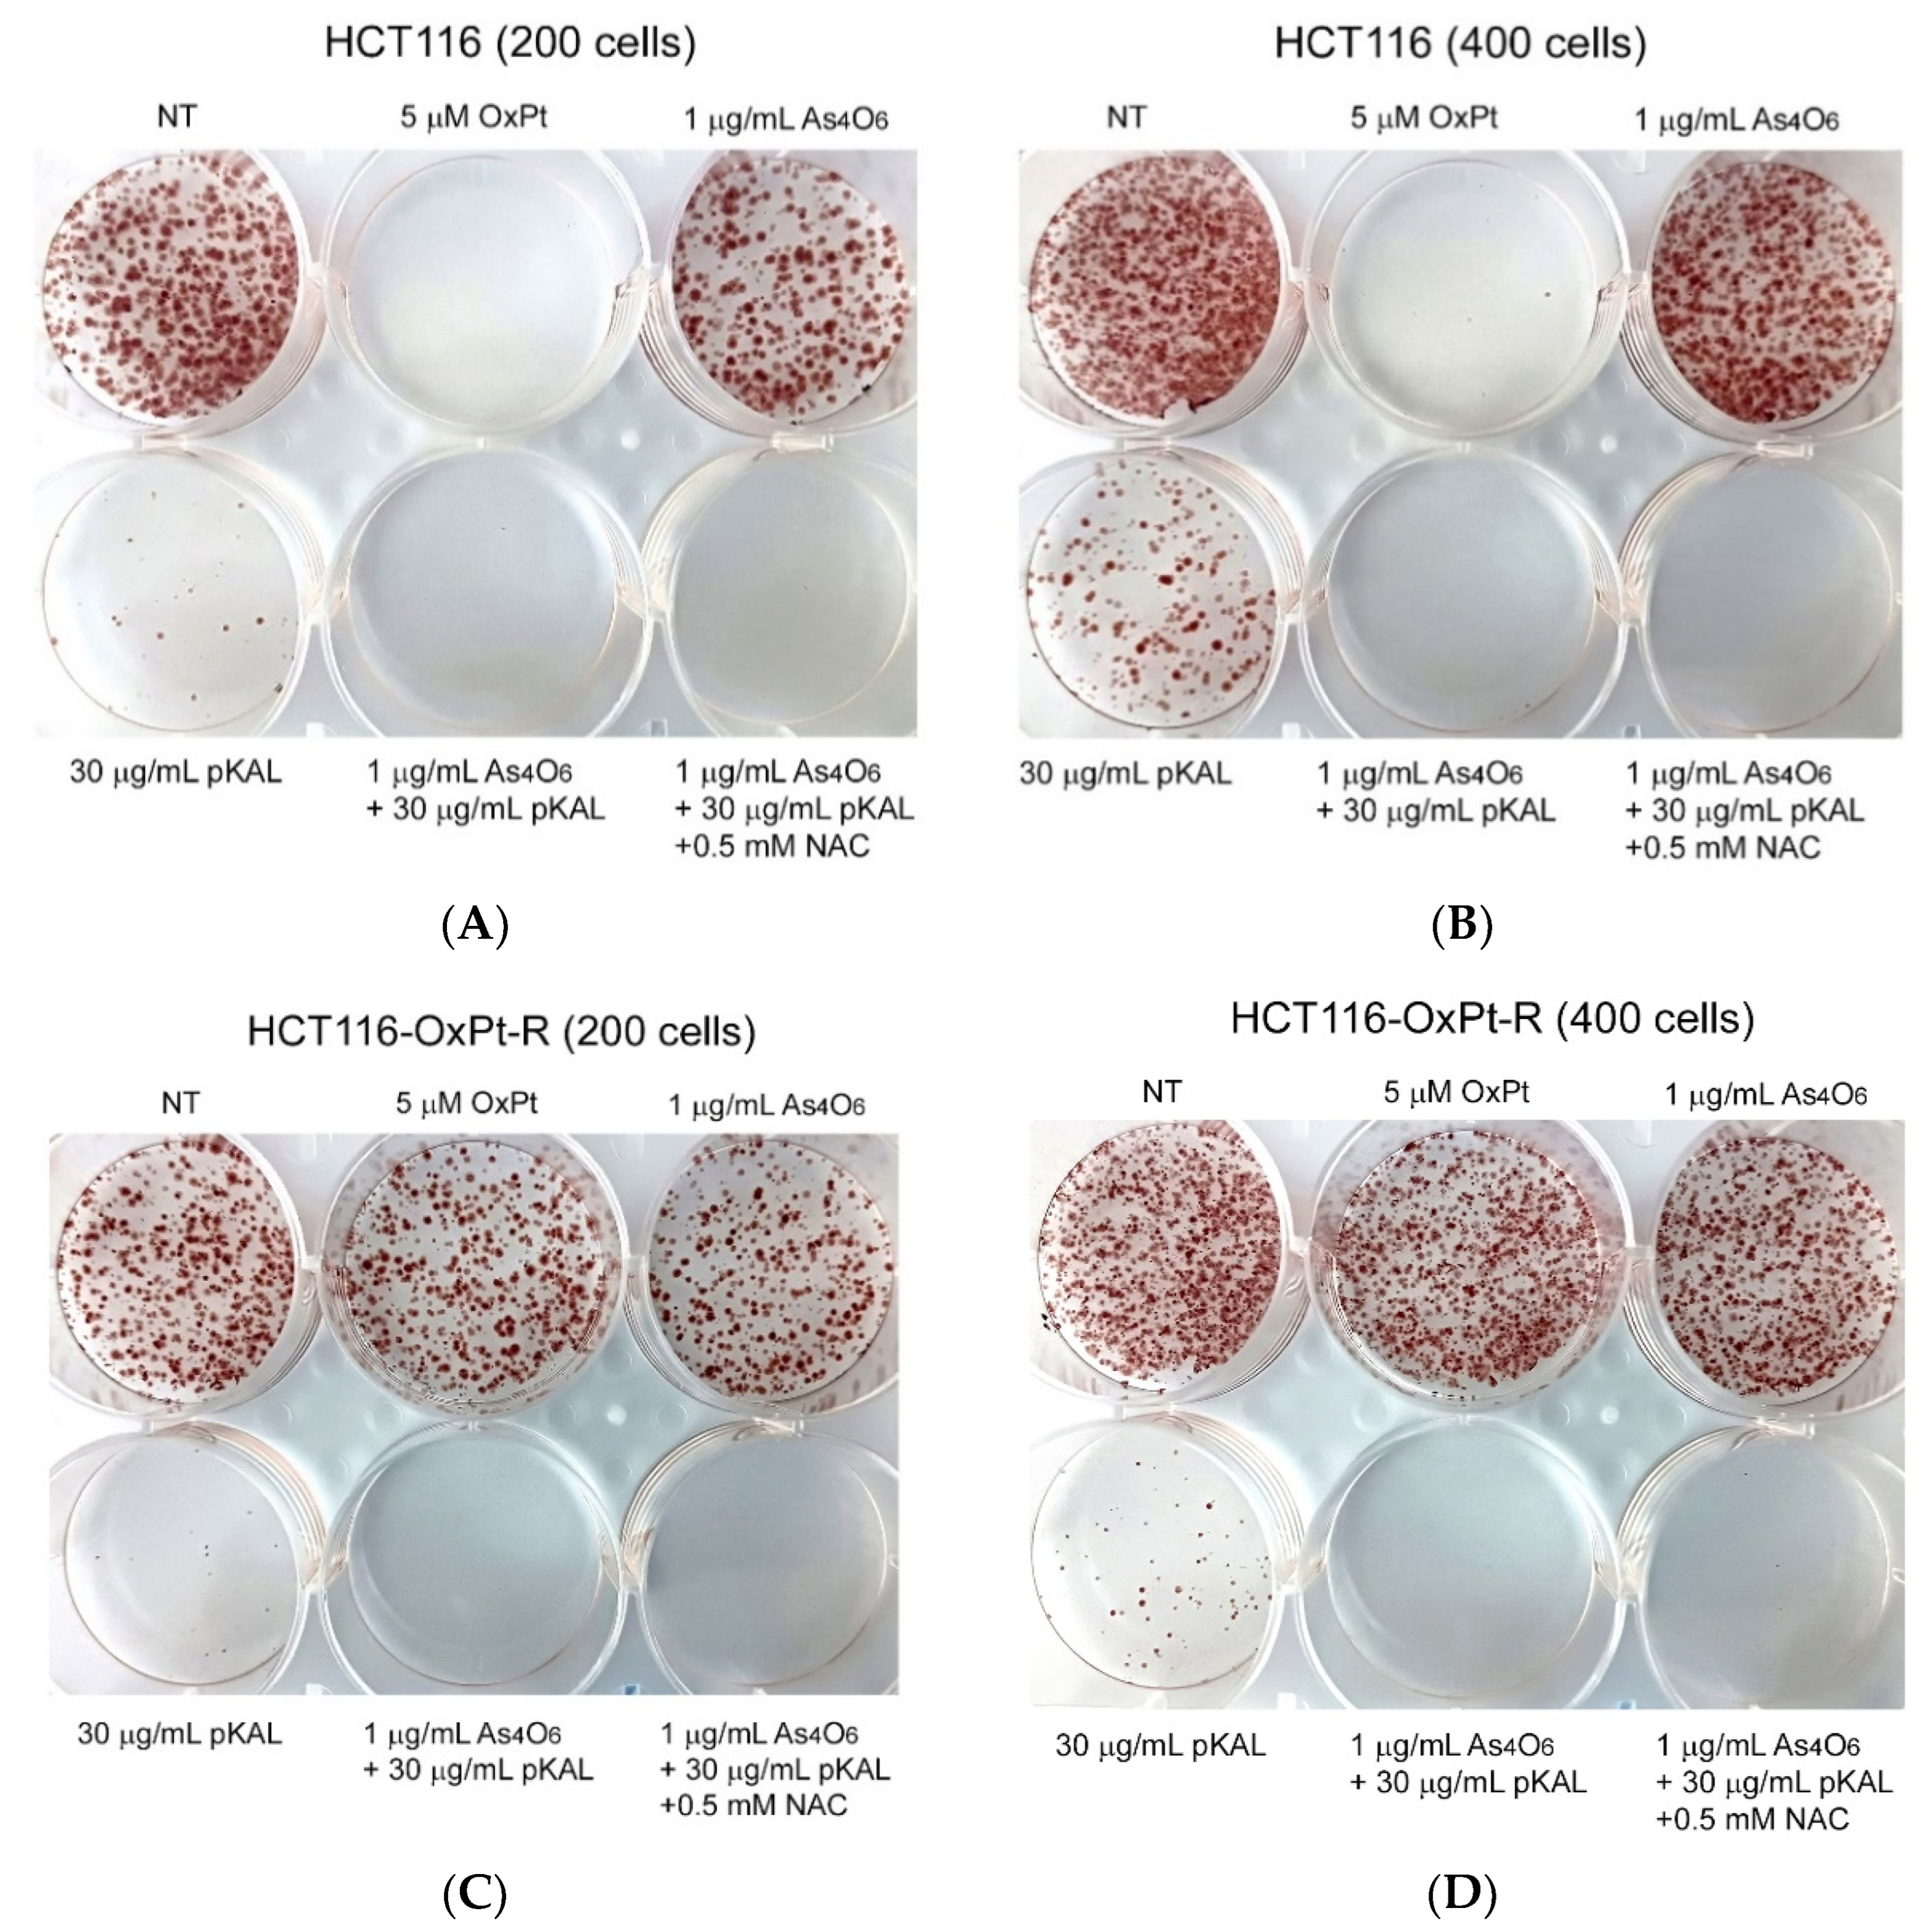
Ijms 26 07661 g009

Tetraarsenic Hexoxide Enhanced the Anticancer Effects of Artemisia annua L. Polyphenols by Inducing Autophagic Cell Death and Apoptosis in Oxalplatin-Resistant HCT116 Colorectal Cancer Cells
Abstract
1. Introduction
2. Results
2.1. Anticancer Effect of As4O6 on the Survial of HCT116 and HCT116-OxPt-R Cells
2.2. Anticancer Effect of Combination Treatment of As4O6 and pKAL on HCT116-OxPt-R Cells
2.3. Induction of Intracellular Vesicles by Combined Treatment of As4O6 and pKAL
2.4. Effect of NAC on the Anticancer Effect of Co-Treatment with As4O6 and pKAL: Differences in the Mechanism of Combined Anticancer Efficacy of As4O6 and pKAL According to Treatment Period
2.5. Confirmation of Autophagic Cell Death Relevance: Effect of Wortmannin (Wort) on the Cooperative Anticancer Effect of As4O6 and pKAL
2.6. Confirmation of Autophagic Cell Death Relevance and Other Cell Death Possibilities: Effect of Wortmannin (Wort) and NAC on the Cooperative Anticancer Effect of As4O6 and pKAL
3. Discussion
4. Materials and Methods
4.1. Materials
4.2. As4O6 and pKAL Compounds
4.3. Cell Culture
4.4. Phase-Contrast Microscopy
4.5. Western Blot Analysis
4.6. Cell Viability Analysis
4.7. Phase-Contrast Microscopy of Hematoxylin-Stained Cells
4.8. Phase-Contrast Microscopy of Trypan Blue-Stained Cells
4.9. Colony Formation Assay
4.10. Statistical Analysis
5. Conclusions
Author Contributions
Funding
Institutional Review Board Statement
Informed Consent Statement
Data Availability Statement
Conflicts of Interest
Abbreviations
| OxPt | Oxaliplatin |
| OxPt-R | Oxaliplatin resistance |
| As4O6 | Tetraarsenic hexoxide |
| pKAL | Polyphenols extracted from Korean Artemisia annua L. |
| LC3B | Microtubule-associated protein 1 light chain 3 beta |
| CD44 | CD44 antigen |
| EGFR | Epidermal growth factor receptor |
| γ-H2AX | Phosphorylated form of histone H2AX on serine 139 |
| PARP1 | Poly(ADP-ribose) polymerase 1 |
| PI3K | Phosphoinositide 3-kinase |
| ROS | Reactive oxygen species |
| NAC | N-acetyl cysteine |
| NRF2 | Nuclear factor erythroid 2-related factor 2 |
| As2O3 | Arsenic trioxide |
| NF-κB | Nuclear factor kappa B |
| FDA | Food and Drug Administration |
| NT | Non-treated |
| ERK | Extracellular signal-regulated kinase |
| GAPDH | Glyceraldehyde-3-phosphate dehydrogenase |
| CCK-8 | Cell counting kit-8 |
| AKT | Protein kinase B (PKB) |
| SOD1 | Superoxide dismutase [Cu-Zn] |
| Wort | Wortmannin |
| HO-1 | Heme oxygenase-1 |
References
- Chian, S.; Li, Y.Y.; Wang, X.J.; Tang, X.W. Luteolin sensitizes two oxaliplatin-resistant colorectal cancer cell lines to chemotherapeutic drugs via inhibition of the Nrf2 pathway. Asian Pac. J. Cancer Prev. 2014, 15, 2911–2916. [Google Scholar] [CrossRef]
- Arango, D.; Wilson, A.J.; Shi, Q.; Corner, G.A.; Aranes, M.J.; Nicholas, C.; Lesser, M.; Mariadason, J.M.; Augenlicht, L.H. Molecular mechanisms of action and prediction of response to oxaliplatin in colorectal cancer cells. Br. J. Cancer 2004, 91, 1931–1946. [Google Scholar] [CrossRef] [PubMed]
- Toscano, F.; Parmentier, B.; Fajoui, Z.E.; Estornes, Y.; Chayvialle, J.A.; Saurin, J.C.; Abello, J. p53 dependent and independent sensitivity to oxaliplatin of colon cancer cells. Biochem. Pharmacol. 2007, 74, 392–406. [Google Scholar] [CrossRef] [PubMed]
- Hsieh, C.C.; Hsu, S.H.; Lin, C.Y.; Liaw, H.J.; Li, T.W.; Jiang, K.Y.; Chiang, N.J.; Chen, S.H.; Lin, B.W.; Chen, P.C.; et al. CHK2 activation contributes to the development of oxaliplatin resistance in colorectal cancer. Br. J. Cancer 2022, 127, 1615–1628. [Google Scholar] [CrossRef] [PubMed]
- Therachiyil, L.; Haroon, J.; Sahir, F.; Siveen, K.S.; Uddin, S.; Kulinski, M.; Buddenkotte, J.; Steinhoff, M.; Krishnankutty, R. Dysregulated Phosphorylation of p53, Autophagy and Stemness Attributes the Mutant p53 Harboring Colon Cancer Cells Impaired Sensitivity to Oxaliplatin. Front. Oncol. 2020, 10, 1744. [Google Scholar] [CrossRef]
- Zhao, B.; Wang, L.; Qiu, H.; Zhang, M.; Sun, L.; Peng, P.; Yu, Q.; Yuan, X. Mechanisms of resistance to anti-EGFR therapy in colorectal cancer. Oncotarget 2017, 8, 3980–4000. [Google Scholar] [CrossRef]
- Martinez-Balibrea, E.; Martinez-Cardus, A.; Gines, A.; Ruiz de Porras, V.; Moutinho, C.; Layos, L.; Manzano, J.L.; Buges, C.; Bystrup, S.; Esteller, M.; et al. Tumor-Related Molecular Mechanisms of Oxaliplatin Resistance. Mol. Cancer Ther. 2015, 14, 1767–1776. [Google Scholar] [CrossRef]
- Jung, E.J.; Kim, H.J.; Shin, S.C.; Kim, G.S.; Jung, J.M.; Hong, S.C.; Kim, C.W.; Lee, W.S. beta-Lapachone Exerts Anticancer Effects by Downregulating p53, Lys-Acetylated Proteins, TrkA, p38 MAPK, SOD1, Caspase-2, CD44 and NPM in Oxaliplatin-Resistant HCT116 Colorectal Cancer Cells. Int. J. Mol. Sci. 2023, 24, 9867. [Google Scholar] [CrossRef]
- Song, Y.; Desta, K.T.; Kim, G.S.; Lee, S.J.; Lee, W.S.; Kim, Y.H.; Jin, J.S.; Abd El-Aty, A.M.; Shin, H.C.; Shim, J.H.; et al. Polyphenolic profile and antioxidant effects of various parts of Artemisia annua L. Biomed. Chromatogr. 2016, 30, 588–595. [Google Scholar] [CrossRef]
- Guo, W.; Wang, W.; Lei, F.; Zheng, R.; Zhao, X.; Gu, Y.; Yang, M.; Tong, Y.; Wang, Y. Identifying the Main Components and Mechanisms of Action of Artemisia annua L. in the Treatment of Endometrial Cancer Using Network Pharmacology. ACS Omega 2024, 9, 8055–8066. [Google Scholar] [CrossRef]
- Howells, L.M.; Sale, S.; Sriramareddy, S.N.; Irving, G.R.; Jones, D.J.; Ottley, C.J.; Pearson, D.G.; Mann, C.D.; Manson, M.M.; Berry, D.P.; et al. Curcumin ameliorates oxaliplatin-induced chemoresistance in HCT116 colorectal cancer cells in vitro and in vivo. Int. J. Cancer 2011, 129, 476–486. [Google Scholar] [CrossRef]
- Ko, Y.S.; Lee, W.S.; Panchanathan, R.; Joo, Y.N.; Choi, Y.H.; Kim, G.S.; Jung, J.M.; Ryu, C.H.; Shin, S.C.; Kim, H.J. Polyphenols from Artemisia annua L Inhibit Adhesion and EMT of Highly Metastatic Breast Cancer Cells MDA-MB-231. Phytother. Res. 2016, 30, 1180–1188. [Google Scholar] [CrossRef]
- Ko, Y.S.; Jung, E.J.; Go, S.I.; Jeong, B.K.; Kim, G.S.; Jung, J.M.; Hong, S.C.; Kim, C.W.; Kim, H.J.; Lee, W.S. Polyphenols Extracted from Artemisia annua L. Exhibit Anti-Cancer Effects on Radio-Resistant MDA-MB-231 Human Breast Cancer Cells by Suppressing Stem Cell Phenotype, beta-Catenin, and MMP-9. Molecules 2020, 25, 1916. [Google Scholar] [CrossRef] [PubMed]
- Jung, E.J.; Paramanantham, A.; Kim, H.J.; Shin, S.C.; Kim, G.S.; Jung, J.M.; Hong, S.C.; Chung, K.H.; Kim, C.W.; Lee, W.S. Identification of Growth Factors, Cytokines and Mediators Regulated by Artemisia annua L. Polyphenols (pKAL) in HCT116 Colorectal Cancer Cells: TGF-β1 and NGF-β Attenuate pKAL-Induced Anticancer Effects via NF-?B p65 Upregulation. Int. J. Mol. Sci. 2022, 23, 1598. [Google Scholar] [CrossRef] [PubMed]
- Yang, M.H.; Chang, K.J.; Li, B.; Chen, W.S. Arsenic Trioxide Suppresses Tumor Growth through Antiangiogenesis via Notch Signaling Blockade in Small-Cell Lung Cancer. BioMed Res. Int. 2019, 2019, 4647252. [Google Scholar] [CrossRef] [PubMed]
- Sun, Z.; Li, M.; Bai, L.; Fu, J.; Lu, J.; Wu, M.; Zhou, C.; Zhang, Y.; Wu, Y. Arsenic trioxide inhibits angiogenesis in vitro and in vivo by upregulating FoxO3a. Toxicol. Lett. 2019, 315, 1–8. [Google Scholar] [CrossRef]
- Kim, M.J.; Jung, J.H.; Lee, W.S.; Yun, J.W.; Lu, J.N.; Yi, S.M.; Kim, H.J.; Chang, S.H.; Kim, G.S.; Hong, S.C.; et al. Arsenic hexoxide enhances TNF-alpha-induced anticancer effects by inhibiting NF-kappaB activity at a safe dose in MCF-7 human breast cancer cells. Oncol. Rep. 2014, 31, 2305–2311. [Google Scholar] [CrossRef]
- Kim, D.; Park, N.Y.; Kang, K.; Calderwood, S.K.; Cho, D.H.; Bae, I.J.; Bunch, H. Arsenic hexoxide has differential effects on cell proliferation and genome-wide gene expression in human primary mammary epithelial and MCF7 cells. Sci. Rep. 2021, 11, 3761. [Google Scholar] [CrossRef]
- Li, X.; Pan, Y.F.; Chen, Y.B.; Wan, Q.Q.; Lin, Y.K.; Shang, T.Y.; Xu, M.Y.; Jiang, T.Y.; Pei, M.M.; Tan, Y.X.; et al. Arsenic trioxide augments immunogenic cell death and induces cGAS-STING-IFN pathway activation in hepatocellular carcinoma. Cell Death Dis. 2024, 15, 300. [Google Scholar] [CrossRef]
- Ahmad, I.M.; Dafferner, A.J.; Salloom, R.J.; Abdalla, M.Y. Heme Oxygenase-1 Inhibition Modulates Autophagy and Augments Arsenic Trioxide Cytotoxicity in Pancreatic Cancer Cells. Biomedicines 2023, 11, 2580. [Google Scholar] [CrossRef]
- Mao, J.; Shi, X.; Hua, L.; Yang, M.; Shen, Y.; Ruan, Z.; Li, B.; Xi, X. Arsenic Inhibits Proliferation and Induces Autophagy of Tumor Cells in Pleural Effusion of Patients with Non-Small Cell Lung Cancer Expressing EGFR with or without Mutations via PI3K/AKT/mTOR Pathway. Biomedicines 2023, 11, 1721. [Google Scholar] [CrossRef] [PubMed]
- Lakshmaiah, K.C.; Chaudhuri, T.; Babu, G.K.; Lokanatha, D.; Jacob, L.A.; Suresh Babu, M.C.; Rudresha, A.H.; Lokesh, K.N.; Rajeev, L.K. Safety and antitumor activity of arsenic trioxide plus infusional 5-fluorouracil, leucovorin, and irinotecan as second-line chemotherapy for refractory metastatic colorectal cancer: A pilot study from South India. Indian J. Cancer 2017, 54, 631–633. [Google Scholar] [CrossRef] [PubMed]
- Yu, G.; Chen, X.; Chen, S.; Ye, W.; Hou, K.; Liang, M. Arsenic trioxide reduces chemo-resistance to 5-fluorouracil and cisplatin in HBx-HepG2 cells via complex mechanisms. Cancer Cell Int. 2015, 15, 116. [Google Scholar] [CrossRef] [PubMed]
- Lee, W.S.; Yun, J.W.; Nagappan, A.; Park, H.S.; Lu, J.N.; Kim, H.J.; Chang, S.H.; Kim, D.C.; Lee, J.H.; Jung, J.M.; et al. Tetraarsenic hexoxide demonstrates anticancer activity at least in part through suppression of NF-κB activity in SW620 human colon cancer cells. Oncol. Rep. 2015, 33, 2940–2946. [Google Scholar] [CrossRef][Green Version]
- Jung, E.J.; Kim, H.J.; Shin, S.C.; Kim, G.S.; Jung, J.M.; Hong, S.C.; Kim, C.W.; Lee, W.S. Artemisia annua L. Polyphenols Enhance the Anticancer. Effect of beta-Lapachone in Oxaliplatin-Resistant HCT116 Colorectal Cancer Cells. Int. J. Mol. Sci. 2023, 24, 17505. [Google Scholar] [CrossRef]
- Moscat, J.; Diaz-Meco, M.T. p62 at the Crossroads of Autophagy, Apoptosis, and Cancer. Cell 2009, 137, 1001–1004. [Google Scholar] [CrossRef]
- Liu, W.J.; Ye, L.; Huang, W.F.; Guo, L.J.; Xu, Z.G.; Wu, H.L.; Yang, C.; Liu, H.F. p62 links the autophagy pathway and the ubiqutin-proteasome system upon ubiquitinated protein degradation. Cell. Mol. Biol. Lett. 2016, 21, 29. [Google Scholar] [CrossRef]
- Itakura, E.; Mizushima, N. p62 targeting to the autophagosome formation site requires self-oligomerization but not LC3 binding. J. Cell Biol. 2011, 192, 17–27. [Google Scholar] [CrossRef]
- Eliopoulos, A.G.; Havaki, S.; Gorgoulis, V.G. DNA Damage Response and Autophagy: A Meaningful Partnership. Front. Genet. 2016, 7, 204. [Google Scholar] [CrossRef]
- Prabhu, K.S.; Kuttikrishnan, S.; Ahmad, N.; Habeeba, U.; Mariyam, Z.; Suleman, M.; Bhat, A.A.; Uddin, S. H2AX: A key player in DNA damage response and a promising target for cancer therapy. Biomed. Pharmacother. 2024, 175, 116663. [Google Scholar] [CrossRef]
- Ihara, M.; Shichijo, K.; Takeshita, S.; Kudo, T. Wortmannin, a specific inhibitor of phosphatidylinositol-3-kinase, induces accumulation of DNA double-strand breaks. J. Radiat. Res. 2020, 61, 171–176. [Google Scholar] [CrossRef]
- Wu, Y.T.; Tan, H.L.; Shui, G.; Bauvy, C.; Huang, Q.; Wenk, M.R.; Ong, C.N.; Codogno, P.; Shen, H.M. Dual role of 3-methyladenine in modulation of autophagy via different temporal patterns of inhibition on class I and III phosphoinositide 3-kinase. J. Biol. Chem. 2010, 285, 10850–10861. [Google Scholar] [CrossRef] [PubMed]
- Blommaart, E.F.; Krause, U.; Schellens, J.P.; Vreeling-Sindelarova, H.; Meijer, A.J. The phosphatidylinositol 3-kinase inhibitors wortmannin and LY294002 inhibit autophagy in isolated rat hepatocytes. Eur. J. Biochem. 1997, 243, 240–246. [Google Scholar] [CrossRef] [PubMed]
- Gilmore, T.D. Introduction to NF-κB: Players, pathways, perspectives. Oncogene 2006, 25, 6680–6684. [Google Scholar] [CrossRef] [PubMed]
- Guttridge, D.C.; Albanese, C.; Reuther, J.Y.; Pestell, R.G.; Baldwin, A.S., Jr. NF-kappaB controls cell growth and differentiation through transcriptional regulation of cyclin D1. Mol. Cell. Biol. 1999, 19, 5785–5799. [Google Scholar] [CrossRef]
- Uribe, M.L.; Marrocco, I.; Yarden, Y. EGFR in Cancer: Signaling Mechanisms, Drugs, and Acquired Resistance. Cancers 2021, 13, 2748. [Google Scholar] [CrossRef]
- Takahashi-Yanaga, F.; Sasaguni, T. GSK-3β regulates cyclin D1 expression:: A new target for chemotherapy. Cell. Signal. 2008, 20, 581–589. [Google Scholar] [CrossRef]
- Perry, J.E.; Grossmann, M.E.; Tindall, D.J. Epidermal growth factor induces cyclin D1 in a human prostate cancer cell line. Prostate 1998, 35, 117–124. [Google Scholar] [CrossRef]
- Takuwa, N.; Fukui, Y.; Takuwa, Y. Cyclin D1 expression mediated by phosphatidylinositol 3-kinase through mTOR-p70(S6K)-independent signaling in growth factor-stimulated NIH 3T3 fibroblasts. Mol. Cell. Biol. 1999, 19, 1346–1358. [Google Scholar] [CrossRef]
- Zhao, Y.X.; Ye, X.C.; Xiong, Z.F.; Ihsan, A.; Ares, I.; Martínez, M.; Lopez-Torres, B.; Martínez-Larrañaga, M.R.; Anadón, A.; Wang, X.; et al. Cancer Metabolism: The Role of ROS in DNA Damage and Induction of Apoptosis in Cancer Cells. Metabolites 2023, 13, 796. [Google Scholar] [CrossRef]
- An, H.; Heo, J.S.; Kim, P.; Lian, Z.; Lee, S.; Park, J.; Hong, E.; Pang, K.; Park, Y.; Ooshima, A.; et al. Tetraarsenic hexoxide enhances generation of mitochondrial ROS to promote pyroptosis by inducing the activation of caspase-3/GSDME in triple-negative breast cancer cells. Cell Death Dis. 2021, 12, 159. [Google Scholar] [CrossRef]
- Spagnuolo, G.; D’Antò, V.; Cosentino, C.; Schmalz, G.; Schweikl, H.; Rengo, S. Effect of N-acetyl-L-cysteine on ROS production and cell death caused by HEMA in human primary gingival fibroblasts. Biomaterials 2006, 27, 1803–1809. [Google Scholar] [CrossRef] [PubMed]
- Montero, P.; Roger, I.; Estornut, C.; Milara, J.; Cortijo, J. Influence of dose and exposition time in the effectiveness of N-Acetyl-l-cysteine treatment in A549 human epithelial cells. Heliyon 2023, 9, e15613. [Google Scholar] [CrossRef] [PubMed]
- Parasassi, T.; Brunelli, R.; Bracci-Laudiero, L.; Greco, G.; Gustafsson, A.C.; Krasnowska, E.K.; Lundeberg, J.; Lundeberg, T.; Pittaluga, E.; Romano, M.C.; et al. Differentiation of normal and cancer cells induced by sulfhydryl reduction: Biochemical and molecular mechanisms. Cell Death Differ. 2005, 12, 1285–1296. [Google Scholar] [CrossRef] [PubMed]
- Chaitanya, G.V.; Steven, A.J.; Babu, P.P. PARP-1 cleavage fragments: Signatures of cell-death proteases in neurodegeneration. Cell Commun. Signal. 2010, 8, 31. [Google Scholar] [CrossRef]
- Okinaga, T.; Kasai, H.; Tsujisawa, T.; Nishihara, T. Role of caspases in cleavage of lamin A/C and PARP during apoptosis in macrophages infected with a periodontopathic bacterium. J. Med. Microbiol. 2007, 56, 1399–1404. [Google Scholar] [CrossRef]
- Mashimo, M.; Onishi, M.; Uno, A.; Tanimichi, A.; Nobeyama, A.; Mori, M.; Yamada, S.; Negi, S.; Bu, X.; Kato, J.; et al. The 89-kDa PARP1 cleavage fragment serves as a cytoplasmic PAR carrier to induce AIF-mediated apoptosis. J. Biol. Chem. 2021, 296, 100046. [Google Scholar] [CrossRef]
- van Wijk, S.J.; Hageman, G.J. Poly(ADP-ribose) polymerase-1 mediated caspase-independent cell death after ischemia/reperfusion. Free Radic. Biol. Med. 2005, 39, 81–90. [Google Scholar] [CrossRef]

Disclaimer/Publisher’s Note: The statements, opinions and data contained in all publications are solely those of the individual author(s) and contributor(s) and not of MDPI and/or the editor(s). MDPI and/or the editor(s) disclaim responsibility for any injury to people or property resulting from any ideas, methods, instructions or products referred to in the content. |
© 2025 by the authors. Licensee MDPI, Basel, Switzerland. This article is an open access article distributed under the terms and conditions of the Creative Commons Attribution (CC BY) license (https://creativecommons.org/licenses/by/4.0/).
Share and Cite
Jung, E.J.; Kim, H.J.; Shin, S.C.; Kim, G.S.; Jung, J.-M.; Hong, S.C.; Kim, C.W.; Lee, W.S. Tetraarsenic Hexoxide Enhanced the Anticancer Effects of Artemisia annua L. Polyphenols by Inducing Autophagic Cell Death and Apoptosis in Oxalplatin-Resistant HCT116 Colorectal Cancer Cells. Int. J. Mol. Sci. 2025, 26, 7661. https://doi.org/10.3390/ijms26167661
Jung EJ, Kim HJ, Shin SC, Kim GS, Jung J-M, Hong SC, Kim CW, Lee WS. Tetraarsenic Hexoxide Enhanced the Anticancer Effects of Artemisia annua L. Polyphenols by Inducing Autophagic Cell Death and Apoptosis in Oxalplatin-Resistant HCT116 Colorectal Cancer Cells. International Journal of Molecular Sciences. 2025; 26(16):7661. https://doi.org/10.3390/ijms26167661
Chicago/Turabian StyleJung, Eun Joo, Hye Jung Kim, Sung Chul Shin, Gon Sup Kim, Jin-Myung Jung, Soon Chan Hong, Choong Won Kim, and Won Sup Lee. 2025. "Tetraarsenic Hexoxide Enhanced the Anticancer Effects of Artemisia annua L. Polyphenols by Inducing Autophagic Cell Death and Apoptosis in Oxalplatin-Resistant HCT116 Colorectal Cancer Cells" International Journal of Molecular Sciences 26, no. 16: 7661. https://doi.org/10.3390/ijms26167661
APA StyleJung, E. J., Kim, H. J., Shin, S. C., Kim, G. S., Jung, J.-M., Hong, S. C., Kim, C. W., & Lee, W. S. (2025). Tetraarsenic Hexoxide Enhanced the Anticancer Effects of Artemisia annua L. Polyphenols by Inducing Autophagic Cell Death and Apoptosis in Oxalplatin-Resistant HCT116 Colorectal Cancer Cells. International Journal of Molecular Sciences, 26(16), 7661. https://doi.org/10.3390/ijms26167661

